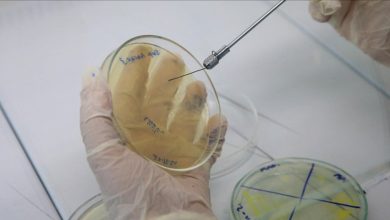

Sağlık
-

Bebeklerde Meme Reddinin Nedenleri ve Çözüm Yolları
Bebeklerde meme reddi ya da memeye küsme durumu, genellikle geçici bir sorun olarak karşımıza çıkmasına rağmen, anneler için zorlu bir…
Devamını Oku » -

Dövmesi Olanların Cilt Kanseri Riski Artıyor
Science Daily‘nin aktardığına göre, Güney Danimarka Üniversitesi ve Finlandiya’daki Helsinki Üniversitesi’nden bilim insanları, dövme mürekkebinin vücuttaki etkilerini anlamak için yaklaşık…
Devamını Oku » -

Sabahları Yorgun Uyanıyorsanız Dikkat! Uyku Apnesinin Tehlikeleri
Uyku apnesi, sadece uyku kalitesini bozmanın ötesinde, Alzheimer ve kalp hastalıkları gibi ciddi sağlık sorunlarının riskini de artırma potansiyeline sahip.…
Devamını Oku » -

Sağlık Bakanı Memişoğlu, İftar Programında Sağlık Çalışanlarıyla Buluştu
Sağlık Bakanı Fahrettin Memişoğlu, 14 Mart Tıp Bayramı vesilesiyle düzenlenen iftar programında sağlık çalışanlarıyla bir araya geldi. İftar, Cumhurbaşkanı Recep…
Devamını Oku » -

Saat 03.00’te Gelen Telefon, Genç Kadının Hayatını Yeniden Şekillendirdi
Kumluca’da yaşayan Filiz Dönmez, 2018 yılında mide bulantısı ve kusma şikayetleri ile hastaneye başvurduğunda, kendisine kronik böbrek yetmezliği teşhisi konuldu.…
Devamını Oku » -

Aile Sağlığı Merkezlerini Güçlendirme Vizyonu
Bakan Memişoğlu, sosyal medya üzerinden yaptığı açıklamada, dün Resmi Gazete’de yayımlanan Sosyal Güvenlik Kurumu Sağlık Uygulama Tebliği’nde yapılan değişikliklere dikkat…
Devamını Oku » -
Erkek Arı Larvası: Bakterilere Karşı Etkili Bir Antibiyotik Alternatifi
Prof. Dr. Nuray Şahinler öncülüğünde gerçekleştirilen bir çalışma, erkek arı larvasının bakteriyel hastalıklar üzerindeki etkisini araştırmak amacıyla yaklaşık bir yıl…
Devamını Oku » -

Bayramda Acil Servisler Alarmda: Kalp Çarpıntısı ve Tansiyon Atağı Artışı!
Bayram sofralarının ardından acil servislere yapılan başvuruların büyük bir kısmının kalp-damar sistemi ile ilişkili olduğunu ifade eden Acil Tıp Uzmanı…
Devamını Oku » -

İdrarda Kan Belirtileri: Nedenleri ve Dikkat Edilmesi Gerekenler
Çocuklarda kırmızı renkli idrar ebeveynler için endişe verici bir durum olabiliyor. Çocuk Sağlığı ve Hastalıkları Uzmanı Dr. Şirin Seçkin, bu…
Devamını Oku » -

Plastik Şişeleri Hayatımızdan Çıkarmanın Zamanı Geldi
Enfeksiyon Hastalıkları ve Klinik Mikrobiyoloji Uzmanı Doç. Dr. Hüsrev Diktaş, plastik şişelerin sağlık açısından ciddi riskler taşıdığını vurguladı. Özellikle bu…
Devamını Oku »

